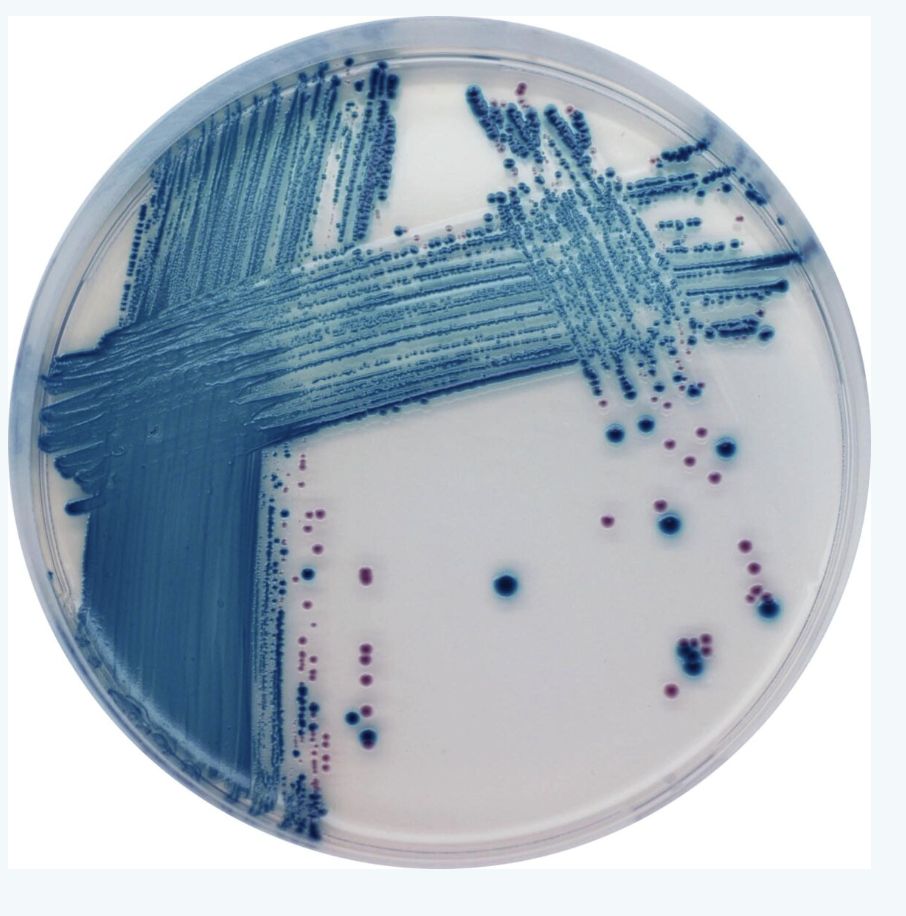
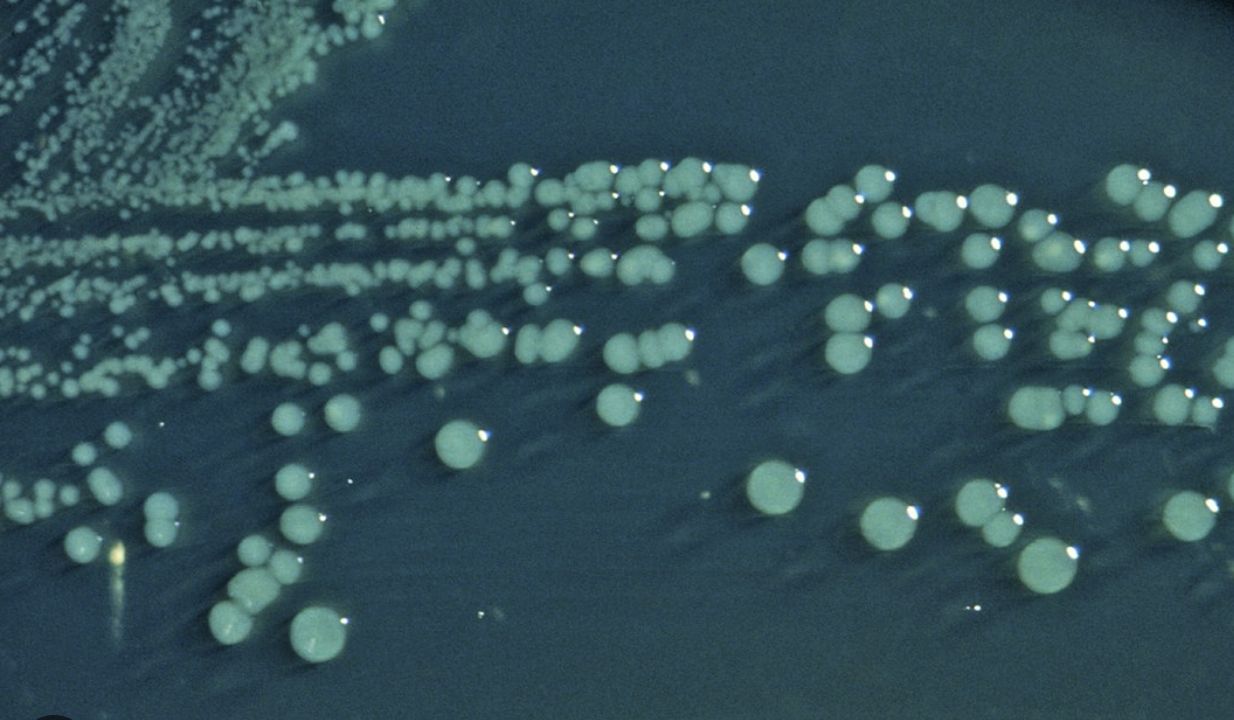

Enteric Infections-Infectious diarrhea
2026-03-01
Enteric Infections- Infectious Diarrhea
Prof. Russell E. Lewis
Department of Molecular Medicine
University of Padua
russelledward.lewis@unipd.it
https://github.com/Russlewisbo
slides available at: www.padovaid.com
 |
Learning objectives
- Identify common causes of infectious diarrhea in adults in developed countries
- Describe patient history and clinical presentation distinguishing viral vs. bacterial causes
- Recognize warning signs for severe diarrheal disease
- Describe management approach and treatment
Overview — Global burden
- Infectious diarrhea: top 10 cause of death worldwide (Troeger et al., 2018)
- 1.7 billion cases annually
- Leading cause of death in children under 5 years (Liu et al., 2016)
- In adults in resource-rich settings: often “nuisance disease” with key clinical decision points
Definitions and duration
Diarrhea
Passage of loose or watery stools
≥3 times in 24 hours
Abnormal stool frequency or consistency
Duration Categories
Acute: <14 days
Persistent: 14-30 days
Chronic: >30 days
Dysentery: diarrhea with visible blood, associated with fever and abdominal pain
Pathophysiology of diarrhea
Normal intestinal physiology
GI tract absorbs 8-9 L fluid daily
Net secretion only 100-200 mL/day
Pathogen virulence factors disrupt this balance
Three mechanisms of pathogen damage
Altered ion absorption/secretion
Disruption of epithelial barrier
Villus atrophy and enzyme deficiency
Small bowel vs. large bowel diarrhea
Small Bowel Pattern
Large volume stools (>200 mL/stool)
Watery consistency
Cramping periumbilical pain - 4-8 stools daily
Associated Symptoms: Nausea/vomiting common, weight loss possible
Large Bowel Pattern
Small volume stools (<200 mL/stool)
Frequent passage (>5-6/day)
Painful tenesmus and urgency
Bloody or mucoid stools
Associated Symptoms - Abdominal cramping/pain -sytemic symptoms less common
Overview of infectious etiologies
- Most diarrhea is viral: stool cultures positive only 1.5-5.6%
- Viral: norovirus (most common), rotavirus, adenoviruses 40/41, astrovirus
- Bacterial: Salmonella, Campylobacter, Shigella, ETEC, EHEC/STEC
- Parasitic: Cryptosporidium, Giardia, Cyclospora, Entamoeba
Norovirus — “The winter vomiting virus”
Key Features
Most common cause of acute gastroenteritis worldwide (Ahmed et al., 2014)
Affects all ages, including highly immune populations
Mean incubation: 24-48 hours - “Winter vomiting disease” (Northern hemisphere)
Norovirus epidemiology & transmission
Viral Characteristics
Non-enveloped RNA virus, Caliciviridae family - Multiple genotypes; no lasting immunity after infection (Patel et al., 2008)
Extremely stable: resists alcohol, chlorine, temperatures to 60°C
Transmission Routes
Primarily fecal-oral >aerosol transmission documented
Fomite transmission (contaminated surfaces)- Can survive environmental conditions for weeks
Norovirus clinical manifestations
Symptoms
Acute onset vomiting (prominent feature)
Watery non-bloody diarrhea (4-8 stools/24 hours)
Fever in 50% of cases
Malaise and headache
Clinical Course
Duration typically 48-72 hours
Complete resolution expected
Dehydration is main complication
Secondary bacterial infection rare
Diagnosis & Management: Clinical diagnosis in outbreak setting - EIA or PCR for confirmation (primarily epidemiologic)
Treatment: supportive care and oral rehydration solution
Norovirus in immunocompromised patients
Unique Clinical Course
Chronic infection: shedding for months to years
Viral evolution occurs during infection
Severe, refractory symptoms possible
May lead to malnutrition and functional decline
Treatment Challenges
No specific antiviral therapy proven effective
Supportive care remains cornerstone
Probiotic therapy: insufficient evidence
Management: supportive nutrition, hydration
Norovirus outbreak management
Prevention Measures
Hand hygiene with soap and water (alcohol ineffective)
Environmental cleaning with chlorine-based disinfectants (0.5-1% bleach)
Surface decontamination: quaternary ammonium compounds
Isolation precautions for symptomatic patients
Outbreak Control
Early detection and reporting to public health
Exclusion of food handlers until 48 hours symptom-free
Restriction of admitted patients in healthcare settings
Rotavirus overview
Epidemiology
Most common cause of severe diarrhea in children worldwide (Parashar et al., 2006) - >100 million cases annually
Approximately 150,000 deaths in children <5 years (Tate et al., 2016)
Peak incidence: 6-24 months age
Clinical Course
Duration 3-8 days , often more severe than norovirus
Dehydration: primary complication
Rotavirus pathophysiology
Viral Characteristics
70 nm non-enveloped RNA virus (Reoviridae family)
Segmented genome with multiple genes encoding virulence factors
Mechanisms of Diarrhea - Villus shortening and disruption - Brush-border enzyme deficiency (lactase, sucrase) - Calcium-dependent enterotoxin production (NSP4) - Impaired water and ion absorption
Rotavirus vaccines
Available Vaccines
RotaTeq (Pentavalent) - Manufactured by Merck - 3-dose series - RV1, RV2, RV3, RV4, RV5
Rotarix (Monovalent) - Manufactured by GSK - 2-dose series - RV1 genotype coverage
Impact on Disease:
Dramatic reduction in hospitalizations (>90%) (Ruiz-Palacios et al., 2006; Vesikari et al., 2006)
$1.2 billion in healthcare cost savings in US per year
Significant reduction in mortality globally in vaccinated populations
Rotavirus — Key clinical points
Typical presentation
Watery, non-bloody diarrhea
Vomiting less prominent than with norovirus
Respiratory symptoms occasionally present (suggests dual viral infection)
Risk factors for severe disease
Age <24 months
Malnutrition
Lack of prior exposure/vaccination
Comorbid conditions
Epidemiology
- Common in daycare settings and seasonal: winter months and dry seasons in temperate climates
Other viral pathogens
| Virus | Age Group | Key Features |
|---|---|---|
| Sapovirus | Children | Similar to norovirus; outbreaks |
| Astrovirus | Young children | Milder than rotavirus |
| Adenovirus 40/41 | Infants/toddlers | Winter seasonality |
| Enteroviruses | Variable | Rash sometimes present |
| Coronaviruses (SARS-CoV-2) |
All ages | Mild GI symptoms often with respiratory |
Bacterial etiologies
Enterotoxigenic E. coli (ETEC) overview
Epidemiology & Pathogenesis
Leading cause of acute diarrhea in developing countries (Qadri et al., 2005)
Survives in water; transmitted via contaminated food/water
Produces enterotoxins: heat-labile (LT) and heat-stable (ST) toxins
Clinical Presentation
Watery diarrhea, often dehydrating
Nausea common; vomiting less frequent
Fever absent or mild
Duration typically 3-5 days
ETEC Toxins and mechanisms
Heat-Labile Toxin (LT)
Similar to cholera toxin
Activates adenylate cyclase
Increases cAMP
Stimulates secretion
Heat-Stable Toxin (ST)
Smaller molecular weight
Activates guanylate cyclase
Increases cGMP
More tissue-specific
Result: Increased intestinal cyclic nucleotides → electrolyte and water secretion → watery diarrhea
Other Pathogenic E. coli Strains
EPEC (Enteropathogenic E. coli)
Primarily affects children <6 months
Contains Eae gene encoding adhesin
Causes attaching and effacing lesions - Non-bloody watery diarrhea
EIEC (Enteroinvasive E. coli)
Invasive mechanism similar to Shigella
Bloody diarrhea with systemic symptoms - Fever and abdominal pain common
EAEC (Enteroaggregative E. coli)
Biofilm formation on epithelium- causes persistent or chronic non-bloody diarrhea (>14 days)
Often associated with travel to developing countries
EHEC/STEC overview
Clinical Significance
Shiga toxin-producing E. coli (STEC) strains
E. coli O157:H7 most common in North America (Karch et al., 2005)
Multiple non-motile serotypes cause disease
Shiga toxin causes microangiopathic hemolytic damage (Tarr et al., 2005)
Hemolytic Uremic Syndrome (HUS)
STEC-Associated HUS
Occurs in approximately 5-15% of STEC infections
Often follows 3-5 days of hemorrhagic diarrhea
Triad: microangiopathic hemolytic anemia (schistocytes on blood smear), thrombocytopenia, acute kidney injury
Prognosis and Sequelae
5-year outcomes: ~70% complete recovery Mortality: 1.4-2.9%
Chronic sequelae: renal dysfunction (8-50%), neurological (5-25%), cardiac (5%)
HUS management
Critical Principle: Avoid Antibiotics !!!
Antibiotic use associated with 25% increase in HUS risk
Proposed mechanism: bacterial lysis releases Shiga toxin
Even fluoroquinolones and azithromycin increase risk
Avoid antimotility agents
HUS Management
Renal replacement therapy: essential in ~50% of cases
Blood product support: transfusions for anemia, platelets carefully
Plasma exchange: controversial but may help neurologic complications
ICU-level supportive care often required
EHEC Detection Methods
Diagnostic Approaches
Sorbitol MacConkey agar: STEC O157:H7 appears non-sorbitol fermenting (colorless)
Chromogenic agar: substrate produces color with specific enzymes
EIA for Shiga toxins: rapid detection from stool
PCR for Stx genes: confirmatory molecular testing
EHEC Outbreaks — Germany 2011
2011 Outbreak Details
Strain: O104:H4 (unusual non-motile strain) (Rasko et al., 2011)
Total infected: 12,600 cases
HUS cases: 4,321
Deaths: 50 (42 from HUS, 8 from sepsis)
Unique Features
Prophage carrying Stx gene plus additional virulence genes
Multidrug resistance including fluoroquinolone resistance
Foodborne outbreak traced to sprouts from Egypt
Deadliest STEC outbreak in modern history
HUS in Italy?
Campylobacter infections
Campylobacter overview
Epidemiology - Most common bacterial cause of gastroenteritis globally (Kaakoush et al., 2015)
- Primarily Campylobacter jejuni (90% of infections) - Also: C. coli, C. lari, and other species
Characteristics
Gram-negative, microaerophilic curved rod
Minimal growth on routine culture media
Fastidious organism; requires special handling
Campylobacter transmission
Animal Reservoir
Common commensal in poultry (colonizes GI tract: 50-90% in GI tract)
- Also found in cattle, pigs, dogs, cats
Undercooked meat: primary source - unpasteurized milk: significant source
Environmental Survival
Survives in freshwater at temperatures <15°C
Sensitive to heat, desiccation, oxygen at room temperature - short survival in food chain; requires careful handling
Direct Transmission
Person-to-person transmission: uncommon but documented
Fecal-oral route primarily - Animal contact risk factor
Campylobacter clinical features
Incubation Period
- Mean: 3 days (range 1-7 days) - Longer than many bacterial pathogens
Typical presentation
Affects both small and large bowel → mixed diarrhea pattern
Watery AND bloody diarrhea common
Febrile prodrome in ~1/3 of cases (fever, malaise, myalgias)
Abdominal pain often prominent and severe
Systemic complications
Bacteremia in 0.1-1% (higher in immunocompromised)
Septic arthritis, osteomyelitis, meningitis (rare)
Post-infectious syndromes (see next slide)
Campylobacter complications
Guillain-Barré Syndrome (GBS)
Estimated 3-40% of GBS cases linked to prior Campylobacter (Nachamkin et al., 1998)
Mechanism: molecular mimicry
Antibodies cross-react with GM1 ganglioside
Ascending paralysis 1-3 weeks after diarrhea
Reactive Arthritis
Occurs in 2.6% of infections
HLA-B27 association
Arthralgia/arthritis weeks after diarrhea
Can be prolonged and disabling
Campylobacter diagnosis
Laboratory Detection
Stool culture on selective media (Campy agar, CCDA agar) -
Requires microaerophilic conditions
Gram-negative, S-shaped or curved rods on microscopy
Culture takes 48-72 hours minimum
Molecular Methods
PCR increasingly available at reference labs
Rapid diagnosis possible
Higher sensitivity than culture
Salmonella infections
Salmonella overview
Epidemiology
Motile gram-negative Enterobacterales
Non-typhoidal: common cause of gastroenteritis (Majowicz et al., 2010)
Typhoidal (S. typhi, S. paratyphi): invasive systemic illness (Crump and Mintz, 2010)
Diversity
>1,400 serotypes identified
Two major clinical syndromes: gastroenteritis vs. enteric fever
Highest incidence globally: South Asia
Non-typhoidal Salmonella epidemiology
Serotype distribution - S. enteritidis: most common globally
S. typhimurium: second most common
Both associated with poultry and poultry products
Transovarial transmission in hens explains egg contamination
Geographic & seasonal patterns
Incidence highest in South and Southeast Asia
Seasonal peaks: summer and autumn in temperate climates
Year-round in tropical regions
Non-typhoidal Salmonella transmission
Non-typhoidal Salmonella clinical features
Incubation Period : 8-72 hours (typically 12-36 hours)
Typical Presentation :
Diarrhea with abdominal pain and cramping
Fever in ~50% (often high—>39°C)
Nausea and vomiting common
Systemic symptoms: malaise, headache
Risk Factors for Severe Disease
- Extremes of age (<5 or >65 years)
- Achlorhydria or antacid use, Inflammatory bowel disease
- Sickle cell disease, immunosuppression
Prognosis
Self-limited in immunocompetent hosts, bacteremia in <5% (higher with underlying conditions)
Duration typically 4-7 days
Non-typhoidal Salmonella — Asymptomatic Carriage
Chronic Carriers
Shedding bacteria >1 year after infection
Prevalence: 0.6-2% of infected individuals
More common with S. enteritidis than other serotypes
Risk factors: female sex, older age, biliary disease
Clinical Implications
Potential source for transmission to others - Important for food handlers and healthcare workers
Prolonged antibiotics (e.g., fluoroquinolone) may clear carriage
Cholecystectomy eradicates infection in some biliary carriers
Enteric/typhoid Fever
Epidemiology : Caused by Salmonella typhi (endemic in South Asia, Africa)
Also S. paratyphi (Asia-Pacific region)
Humans are the only reservoir - ~21 million cases and 200,000 deaths annually globally
Mortality 1-4% with treatment; 20-30% without
Risk Factors for Acquisition - Travel to endemic areas (South Asia especially)
Poor sanitation exposure
Close contact with chronic carriers
Typhoid fever — Clinical progression
Week 1: Septicemia Phase
- Gradual fever onset (prodrome over days)
- High fever develops, continuing to rise
- Bacteremia present
- Relative bradycardia (unusual for degree of fever)
- Malaise, headache, myalgias
Week 2-3: Systemic Phase
- Sustained high fever (often continuous pattern—“staircase fever”)
- Rose spots rash (evanescent, 2-3mm rose-colored papules on trunk)
- Hepatosplenomegaly with abdominal pain and distension, diarrhea or constipation
Week 3-4: Crisis Phase
Risk of intestinal perforation (Peyer’s patches ulcerate)
Septic shock possible
Delirium and altered mental status (“typhoid state”)
Myocarditis, pneumonia
Typhoid fever — Treatment
Antimicrobial challenges
Fluoroquinolone resistance increasing in South Asia
Multidrug-resistant strains (TMP/SMX, chloramphenicol, ampicillin) common
Extensively drug-resistant (XDR) strains emerging
Treatment options - First-line (susceptible): Fluoroquinolone (ciprofloxacin)
Alternatives: Third-generation cephalosporins (ceftriaxone, cefixime)
Resistant strains: Azithromycin (5-day course) for nalidixic acid-resistant strains
Duration: 7-14 days depending on severity and response
Prognosis with treatment - Defervescence typically 4-6 days after starting therapy
- Relapse possible 1-2 weeks after apparent cure - Follow-up cultures recommended to document clearance
Shigella overview
Microbiology
Non-motile gram-negative Enterobacterales
Four serogroups: dysenteriae, flexneri, boydii, sonnei (Kotloff et al., 2018)
Humans are the only reservoir (crucial difference from Salmonella)
Clinical Significance
Third most common bacterial cause of diarrhea (after Salmonella and Campylobacter)
Associated with severe dysentery and complications
Rapid person-to-person spread in closed environments
Shigella pathophysiology and complications
Virulence Mechanisms
Invasion of colonic epithelium (ipaB, ipaC genes)
Intracellular multiplication - abscess formation and mucosal ulceration
Enterotoxin production: ShET1, ShET2
Complications
Shiga toxin produced by S. dysenteriae → HUS possible - HUS occurs in ~8% of children with S. dysenteriae infection
Toxic megacolon (rare)
Protein-calorie malnutrition from persistent diarrhea
Seizures, febrile delirium (especially in children)
Shigella diagnosis and treatment
Laboratory Diagnosis
Stool culture on selective media (HE agar, XLD agar)
Preferred: culture from mucoid/blood-stained stool
Non-motile gram-negative colonies - PCR for Stx gene (S. dysenteriae)
Resistance Patterns
Asia/Africa: 20-30% resistance to third-generation cephalosporins
TMP/SMX resistance: 65-85% in some regions
Fluoroquinolone resistance increasing (esp. S. sonnei in Asia)
Treatment
First-line: Fluoroquinolone or ceftriaxone (when fluoroquinolone susceptibility uncertain)
Alternative: Azithromycin
Duration: 5-7 days
Shigella — When to treat
Standard Recommendation
Most infections resolve without antibiotics
Treatment doesn’t significantly alter outcomes in mild-moderate disease
Treat When
Immunocompromised patients (including HIV)
Severe diarrhea or dysentery
Bacteremia or extraintestinal infection
High risk for transmission (food handlers, daycare workers)
Benefit of Treatment
Decreases symptom duration by ~2 days
Reduces fecal shedding (may reduce transmission)
Prevents complications in vulnerable populations
Yersinia
Species of clinical importance:
- Yersinia enterocolitica - Yersinia pseudotuberculosis
Key characteristics - Zoonotic infections: wild and domestic animals
Transmission: undercooked pork, contaminated water
Can survive refrigeration (cold enrichment aids culture)
Clinical features : Watery diarrhea or dysentery
Distinctive: pharyngitis in ~20% (pharyngitis-gastroenteritis pattern)
Acute mesenteric lymphadenitis: can mimic appendicitis
Fever and abdominal pain prominent
Can cause arthralgia (particularly HLA-B27 associated)
Lab diagnosis - Culture on selective media (CIN agar)
- Overgrowth by normal flora; requires selective medium or cold enrichment
John Snow- Birth of medical epidemiology
Vibrio cholerae
Epidemiology
- Endemic in South Asia (particularly Bangladesh, India) (Sack et al., 2004)
- Seventh pandemic ongoing since 1961
- Transmitted via contaminated water in areas with poor sanitation
- Epidemic potential high; 3-5 million cases, 100,000-300,000 deaths annually (Ali et al., 2015)
Clinical Presentation
- Acute watery non-bloody diarrhea
- Characteristic “rice-water stools” (clear, watery, with flecks)
- Severe dehydration and shock possible
- Vomiting common
- Can be fulminant with progression to hypovolemic shock
Cholera management
Diagnostic approach
Culture on TCBS (Thiosulfate-Citrate-Bile Salts) agar
Oxidase-positive, gram-negative curved rods
PCR available at reference labs
Treatment
Fluid replacement is paramount!!!
Oral rehydration solution (ORS) is first-line
IV fluids (normal saline or Ringer’s lactate) for severe dehydration
Replacement volumes can be massive (10-20 L/day in severe cases)
Monitor for electrolyte abnormalities
Antimicrobial therapy
Decreases duration and volume of diarrhea
Doxycycline, fluoroquinolones, or azithromycin
Secondary to fluid replacement in priority
Prevention - Vaxchora: oral cholera vaccine for travelers to endemic areas
- Provides ~90% protection for 3 months, wanes thereafter - Food and water precautions essential
Traveler’s Diarrhea
Traveler’s diarrhea — Overview
Epidemiology
Affects 300-500 million travelers annually
Attack rate varies by destination: 5-50% depending on region (Steffen et al., 2015)
Onset typically 5-15 days after arrival in endemic region
Duration usually 1-5 days (self-limiting in 90%)
Clinical Presentation
Watery diarrhea most common (80%)
Some bloody stools possible (10-20%)
Fever in 20-30%
Cramping abdominal pain
Systemic symptoms mild
Definition
≥3 unformed stools in 24 hours plus 1+ GI symptom
Occurring in someone traveling to area of higher risk
Traveler’s diarrhea — Etiology by region
| Pathogen | Frequency | Geographic Notes |
|---|---|---|
| ETEC | 40-50% | Most common worldwide |
| Campylobacter jejuni | 5-30% | Higher in Asia |
| Salmonella spp. | 5-20% | Variable by region |
| Shigella spp. | 5-15% | Higher in developing regions |
| Enteroinvasive E. coli | 5-10% | Variable |
| Protozoa (Giardia, Crypto) | 2-5% | More in rural areas |
| Viral | 5-10% | Norovirus, Rotavirus, Adenovirus |
| Noninfectious | 10-20% | Dietary changes, altitude |
Traveler’s diarrhea — Prevention
Food and water precautions
Drink bottled or boiled water
Avoid ice, raw vegetables, raw/undercooked meat
Peel own fruits
Avoid street food and unpasteurized dairy
Antimicrobial prophylaxis
Not routinely recommended (resistance, adverse effects)
Consider for high-risk patients (immunocompromised, severe underlying disease)
Bismuth subsalicylate: effective prophylaxis (2 tablets QID)
Duration: maximum 3 weeks
Traveler’s Diarrhea — Self-treatment
Treatment Options
Preferred Approach
Azithromycin 500 mg once daily, 3 days (Riddle et al., 2016)
Covers ETEC, Campylobacter, Shigella
Lower resistance rates than fluoroquinolones
Alternative Approaches
Fluoroquinolone (levofloxacin, ciprofloxacin) if available
Rifaximin 200 mg TID, 3 days (non-absorbed, minimal resistance)
Symptomatic Therapy - Loperamide (Imodium): effective for cramping
- Combine with antibiotic for faster resolution - Bismuth subsalicylate: both treatment and symptomatic relief
Diarrhea in HIV/AIDS
Epidemiology
Affects 30-60% of patients with AIDS (CD4 <200) (Sanchez et al., 2005)
Incidence decreased markedly with antiretroviral therapy
ART with immune reconstitution reduces diarrheal disease
Infectious Etiologies in AIDS
Cryptosporidium parvum: most common parasitic cause
Cytomegalovirus: causes ulcerative colitis pattern
Microsporidium: can cause chronic diarrhea
Mycobacterium avium complex: systemic infection
Conventional pathogens remain common (Salmonella, Campylobacter)
Management - Start/optimize antiretroviral therapy (most important) - Ganciclovir for CMV colitis - Multipathogen testing recommended - Empiric therapy based on CD4 count and epidemiology
Diarrhea in transplant recipients
Frequency and Timing
50-80% of solid organ transplant (SOT) recipients experience diarrhea
Varies by organ type and immunosuppression level -
Can occur months to years post-transplant
Infectious Etiologies
Clostridioides difficile: most common infectious cause (9-20% incidence) (McDonald et al., 2018)
Norovirus: prolonged shedding common
Cryptosporidium, Giardia, Cyclospora
Cytomegalovirus: ulcerative colitis pattern
Noninfectious Causes - Up to 66% of cases in some series - medication side effects (mycophenolate, tacrolimus) , sorbitol-containing medications, IBD-like inflammation (idiopathic)
Diagnostic Approach - Multipathogen testing essential (stool culture, EIA, PCR)
- Consider colonoscopy with biopsy - Address immunosuppression optimization
Diarrhea in immunocompromised patients — General approach
Key Diagnostic Principles
Identify etiologic agent whenever possible (broad differential)
Multipathogen testing: stool culture, parasitic studies, molecular panel
Lower threshold for colonoscopy and biopsy
Consider unusual pathogens based on immune defect
Treatment Considerations
Pathogen-specific therapy when identified
Avoid empiric broad-spectrum antibiotics when possible
Address underlying immune defect (ART, immunosuppression optimization)
Monitor for immune recovery inflammation (MAC disease, IRIS)
Hospital-acquired diarrhea
Epidemiology: Occurs in 10-15% of hospitalized patients
Clostridioides difficile: most common infectious cause (Lessa et al., 2015)
Associated with increased morbidity, mortality, and healthcare costs
Risk factors: Recent or current antimicrobial therapy (strongest risk factor)
Advanced age
Severity of underlying illness
Prolonged hospitalization
Immunosuppression
Clinical features : Occurs after ≥3 days hospitalization
Watery diarrhea most common
Fever, leukocytosis, abdominal pain -
Can progress to toxic megacolon or perforation
C. difficile-associated disease
Toxin-mediated disease (toxin A, toxin B) -Antimicrobial exposure disrupts normal flora
Transmission via spores: contact precautions required (hand sanitizer not sufficient)
Increasing incidence of severe, recurrent disease
Diarrhea in institutional settings
Long-Term Care Facilities
One-third of residents experience diarrhea annually
C. difficile most common
Rotavirus, G. lamblia seasonal outbreaks
Norovirus rapid spread in winter
Nutritional impact: worsens outcomes in elderly
Daycare and School Settings
Rotavirus common in young children (prior to universal vaccination)
G. lamblia outbreaks in daycare
Shigella spread via fecal-oral route
ETEC in contaminated water/food
Exclusion policies important for control
Neonatal diarrhea
Often caused by EPEC serotypes
Risk of severe dehydration in newborns
Historical mortality 24-50%; now <5% with rehydration therapy
Insidious onset; requires high clinical suspicion - May present with failure to thrive
Principles of treatment — Rehydration
Oral Rehydration Solution (ORS)
First-line for mild-moderate dehydration
WHO-recommended formulation: sodium 75 mmol/L, glucose 75 mmol/L, chloride 65 mmol/L, potassium 20 mmol/L
Effective for >90% of acute diarrhea cases
Rehydration Approach
Replace ongoing losses (10 mL/kg per stool)
Add maintenance fluids
Early rehydration prevents severe dehydration
Resume age-appropriate diet early
IV Rehydration - Reserved for severe dehydration, vomiting, shock
Normal saline or Ringer’s lactate preferred
Careful electrolyte monitoring - Transition to oral when feasible
Symptomatic treatment
Bismuth Subsalicylate
Reduces diarrheal volume by 30-50%
Antimicrobial properties against several pathogens
Useful for both prophylaxis and treatment
Avoid in salicylate allergy; concern for drug interactions - Useful in traveler’s diarrhea management
Antimotility Agents: Use with Caution - Loperamide (Imodium): effective for cramping
Risk: can precipitate toxic megacolon (contraindicated in bloody diarrhea, fever, severe disease)
Never use with suspected EHEC
Combined with antibiotics: effective for traveler’s diarrhea
Generally safe in mild, watery, non-inflammatory diarrhea
Probiotics
Insufficient evidence for general recommendation
May be role in specific contexts (antibiotic-associated diarrhea)
Not harmful but not proven beneficial in most diarrhea
When to use antibiotics
Empiric Antibiotics Recommended For:
Severe diarrhea (bloody, fever, >8 stools/day)
Diarrhea in immunocompromised patients
Traveler’s diarrhea (if symptomatic treatment not effective)
Suspected invasive pathogen (Salmonella bacteremia, Shigella in systemically ill)
Institutional outbreaks (control transmission)
Avoid Antibiotics: Suspected or confirmed EHEC/STEC (increases HUS risk)
Viral diarrhea - Mild, watery, non-bloody diarrhea in immunocompetent hosts
Non-typhoidal Salmonella gastroenteritis in most patients
First-Line Empiric Choices
Azithromycin 500 mg daily × 3 days (preferred for traveler’s diarrhea)
Fluoroquinolone (ciprofloxacin 500 mg BID × 3 days) where resistance is low
Adjust based on local resistance patterns
Micronutrient supplementation
Zinc Supplementation
Particularly in children <5 years in developing countries (Lazzerini and Wanzira, 2016)
Reduces duration and severity of diarrhea
Decreases risk of subsequent infections for 2-3 months
Dose: 10-20 mg elemental zinc daily for 10-14 days
Strong evidence supports benefit, especially in malnourished children
Other Micronutrients
Vitamin A: benefit in deficient populations
Iron: avoid during acute infection (may worsen)
Folate, B vitamins: supportive during recovery
Role in Developed Countries - Less emphasis (better nutritional status baseline) - Consider in malnourished or vulnerable populations - Not harmful if administered
Key Take-Home Messages
Most diarrhea is viral and self-limited — reserve specific testing and antibiotics for cases suggesting bacterial infection
Rehydration is the cornerstone of treatment — ORS is highly effective and first-line for most cases (Munos et al., 2010)
Identify patients needing hospitalization or antibiotics — use clinical features, history, and exam to guide severity assessment and testing
EHEC/STEC demands special attention — antibiotics are contraindicated and increase HUS risk
Geographic and risk-factor epidemiology matters — tailor diagnostic approach and empiric therapy based on exposure history and patient factors
Clinical decision Framework
Dehydration • Vital signs • Systemic symptoms
⚠ Red flags: bloody stools | fever >39°C | altered mental status | shock
Travel • Food/water exposure • Sick contacts • Immunocompromise • Recent antibiotics • Medications
• Fever >38.5°C
• Systemic illness
• Immunocompromised
• Duration >7 days
• No red flags
• Immunocompetent host
Rehydration — first-line for all Antibiotics — only if bacterial criteria met; avoid for EHEC Symptomatics — if no contraindications
References
Troeger C, et al. Estimates of the global, regional, and national morbidity, mortality, and aetiologies of diarrhea in 195 countries: a systematic analysis for the Global Burden of Disease Study 2016. Lancet Infect Dis. 2018.
Liu L, et al. Global, regional, and national causes of child mortality in 2000-13, with projections to inform post-2015 priorities. Lancet. 2015.
Freedman SB, et al. Pediatric Gastroenteritis in Developed and Developing Countries. Gastroenterology. 2020.
Platts-Mills JA, et al. Pathogen-specific burdens of community diarrhoea in developing countries. Lancet Glob Health. 2015.